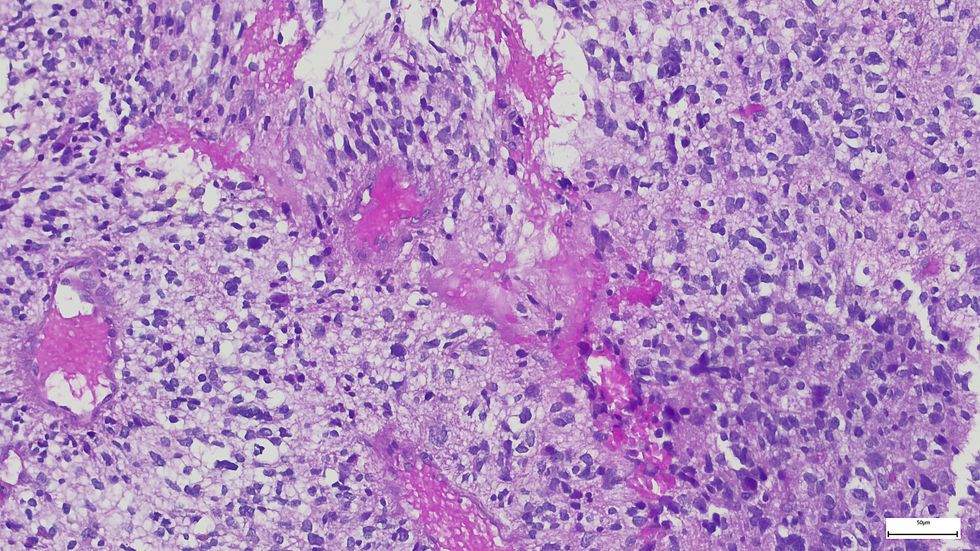
Cancer cells under microscope

'I spotted cancer in my healthy husband's mouth - a 30-second mouth check after brushing could save your life'

WATCH NOW: NHS Scotland launches AI trial to help detect lung cancer and strokes in X-rays
|GBN

A dentist's personal experience has turned her into an advocate for self-screening
Don't Miss
Most Read
Latest
Mouth cancer cases and deaths are climbing substantially across the UK, making it an increasingly serious health concern. Thankfully, a simple half-minute routine after brushing your teeth could potentially save your life.
This quick self-check takes just moments but could catch early warning signs that might otherwise go unnoticed. It is particularly important because oral cancer can affect anyone - even those who are young, healthy and have never smoked.
Dr Ashley Joves is now on a mission to spread awareness about this easy screening technique after her own family's experience. Her story shows why taking those extra 30 seconds in front of the mirror matters so much.
The dentist made a devastating discovery just four weeks ago when she found oral cancer in her own husband's mouth.
TRENDING
Stories
Videos
Your Say

Ashley discovered cancer in her husband's mouth
|TIKTOK / ASHLEYJOVESDDS
What made this particularly shocking was that her husband is young, healthy and has never smoked - not the typical profile many associate with mouth cancer.
"I'm going to show you why spending an extra 30 seconds after brushing your teeth can potentially save your life," Ashley explained.
Having witnessed first-hand how oral cancer can strike unexpectedly, she's determined to help others avoid what her family has endured over the past month.
Ashley walks through exactly how to perform this potentially life-saving check at home, especially helpful for those without regular dental visits. "It is as easy as sticking the tongue out in the mirror," she explained.
Start by extending your tongue as far as possible to each side.
Then lift it up to examine both the floor of your mouth and the tongue's underside.
Next, open wide to inspect the back of your throat and check the inside of your lips and feel around for any lumps, bumps or unusual areas. Finally, examine your cheeks thoroughly.
"What you're looking for is something that doesn't belong," Ashley noted, explaining that a healthy tongue should appear pink throughout.
LATEST DEVELOPMENTS:
The dentist warned that any lesion appearing white, red or irregular, particularly if it's only on one side of the mouth, needs professional attention.
"If there is a lesion that looks white, red, irregular or on one side of the mouth, have a professional take a look, call a dentist," she urged viewers.
Lesions in the mouth could be a sign of cancer
|GETTY
The expert also urged trusting your instincts, as her husband's first biopsy came back benign, but Ashley wasn't convinced.
A second test confirmed cancer, and thankfully, he's now cancer-free and alive.
While tobacco use, heavy alcohol consumption and HPV infection remain the primary risk factors for mouth cancer, Ashley's experience proves it can affect anyone.
She concluded that her mission is now to ensure others don't face what her family has endured.
Our Standards: The GB News Editorial Charter










